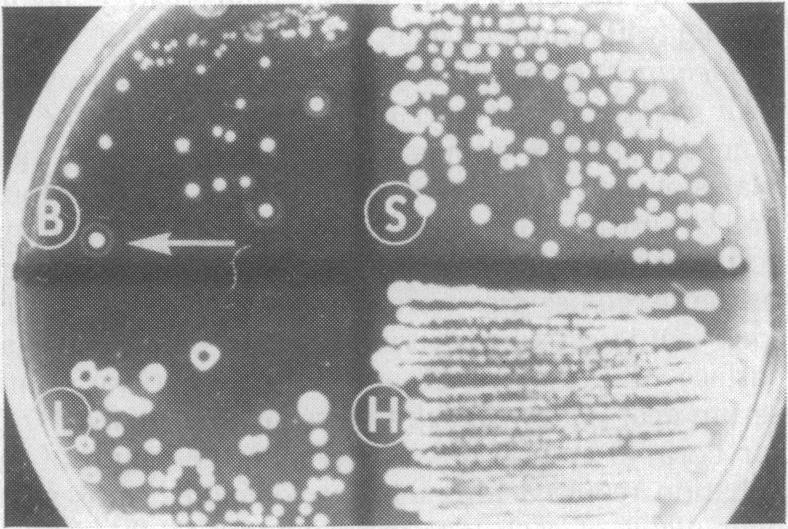

使用抗血清琼脂平板技术对鼠疫耶尔森菌进行特异性鉴定和分离。
Use of the antiserum-agar plate technique for specific identification and isolation of Pasteurella pestis.
作者信息
Albizo J M, Surgalla M J
出版信息
Appl Microbiol. 1968 Aug;16(8):1114-9. doi: 10.1128/am.16.8.1114-1119.1968.
Pasteurella pestis colonies were specifically identified on antiserum-agar plates used for primary culture of tissues from experimentally infected guinea pigs. Both selective and nonselective antiserum-agar plates were used to identify P. pestis from guinea pigs kept at 22 C for periods up to 4 days after death from plague. Colonies identified as P. pestis on selective and nonselective antiserum-agar plates, by the appearance of precipitin rings following brief chloroform vapor treatment, remained viable and were subsequently purified on nonselective antiserum-agar plates. Isolates obtained in this manner were uniformly lethal when injected into mice and guinea pigs, and conformed to standard laboratory criteria for P. pestis. P. pestis was identified on selective antiserum-agar plates from the spleens of all guinea pigs killed by the isolates, and from a large majority of the mice. The practical value and confirmative nature of the method were demonstrated.
在用于对实验感染豚鼠的组织进行初次培养的抗血清琼脂平板上,特异性鉴定出了鼠疫耶尔森菌菌落。使用选择性和非选择性抗血清琼脂平板,从死于鼠疫后在22℃保存长达4天的豚鼠中鉴定鼠疫耶尔森菌。通过短暂氯仿蒸汽处理后出现沉淀环,在选择性和非选择性抗血清琼脂平板上鉴定为鼠疫耶尔森菌的菌落保持存活,随后在非选择性抗血清琼脂平板上进行纯化。以这种方式获得的分离株注射到小鼠和豚鼠体内时均具有致死性,并且符合鼠疫耶尔森菌的标准实验室标准。在所有被分离株致死的豚鼠脾脏以及大多数小鼠的脾脏中,在选择性抗血清琼脂平板上鉴定出了鼠疫耶尔森菌。证明了该方法的实用价值和确证性质。